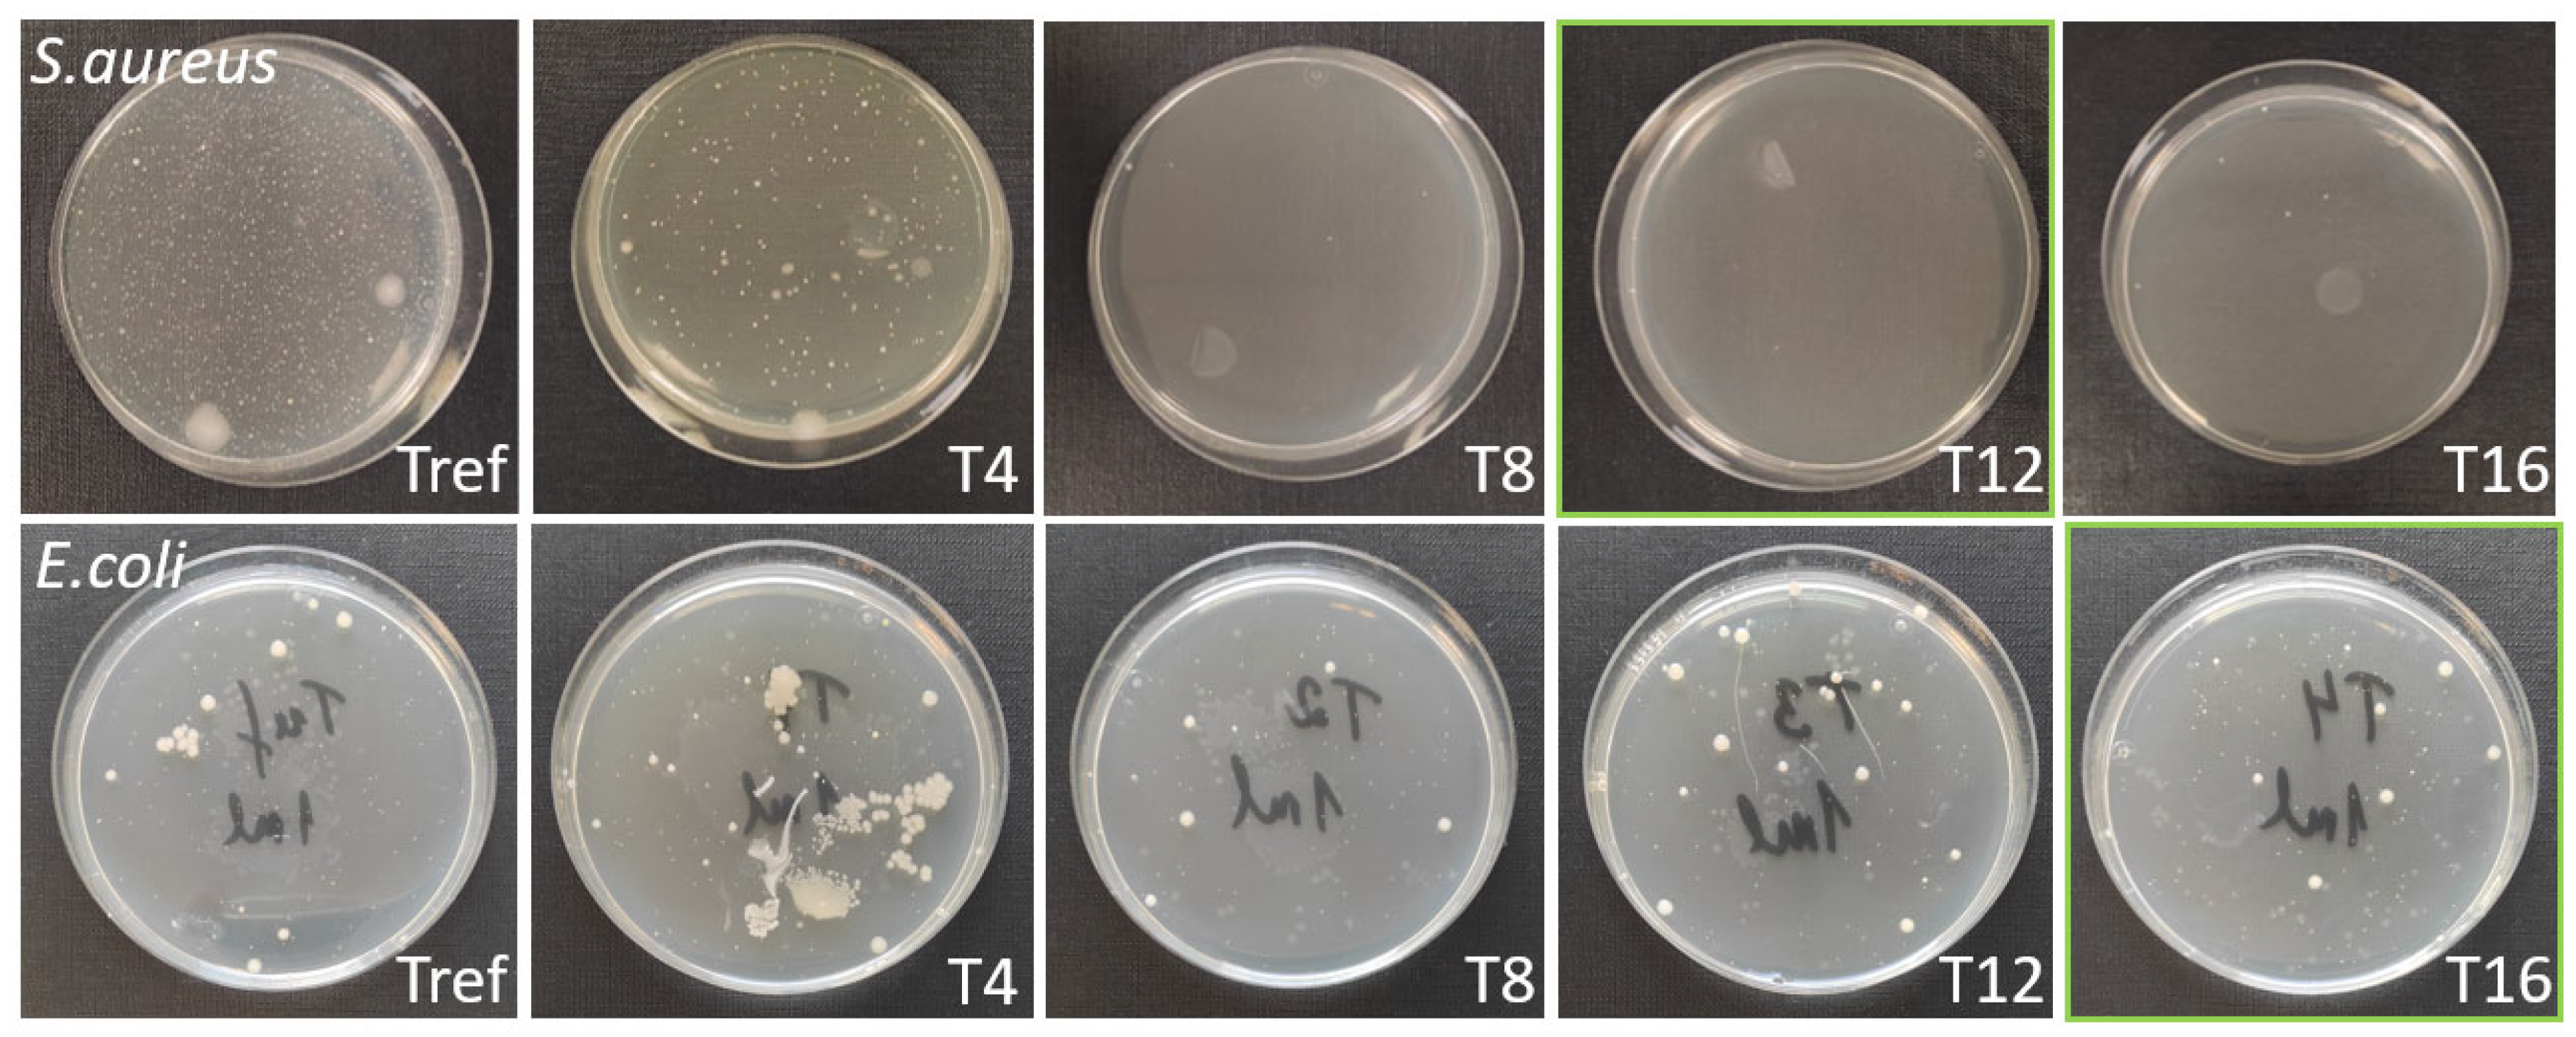
Nanomaterials 13 02032 g010

Effect of Femtosecond Laser-Irradiated Titanium Plates on Enhanced Antibacterial Activity and Preservation of Bacteriophage Stability
Abstract
1. Introduction
2. Materials and Methods
2.1. Materials and Laser Setup
2.2. Characterization of Titanium Plates before and after Irradiation
2.2.1. Scanning Electron Microscopy (SEM) Analysis
2.2.2. X-ray Photoelectron Spectroscopy (XPS) Analysis
2.2.3. Raman Spectroscopy
2.2.4. Atomic Force Microscopy (AFM)
2.3. Wettability
2.4. Antibacterial Properties
2.5. Preparation of Bacteriophage Solution and Its Exposure to Titanium Plates
2.5.1. Preparation of the Bacteriophage Solution
2.5.2. Preparation of Mixtures of Bacteriophage Solutions and Titanium Plates
2.5.3. Determination of Bacteriophage Stability
2.5.4. Statistical Analysis
3. Results and Discussion
4. Conclusions
Author Contributions
Funding
Data Availability Statement
Conflicts of Interest
References
- Lin, Z.; Liu, K.; Cao, T.; Hong, M. Microsphere Femtosecond Laser Sub-50 Nm Structuring in Far Field via Non-Linear Absorption. Opto-Electron. Adv. 2023, 6, 230029. [Google Scholar] [CrossRef]
- Arango-Santander, S.; Pelaez-Vargas, A.; Freitas, S.C.; García, C. A Novel Approach to Create an Antibacterial Surface Using Titanium Dioxide and a Combination of Dip-Pen Nanolithography and Soft Lithography. Sci. Rep. 2018, 8, 15818. [Google Scholar] [CrossRef] [PubMed]
- Russo, P.; Liang, R.; He, R.X.; Zhou, Y.N. Phase Transformation of TiO2 Nanoparticles by Femtosecond Laser Ablation in Aqueous Solutions and Deposition on Conductive Substrates. Nanoscale 2017, 9, 6167–6177. [Google Scholar] [CrossRef] [PubMed]
- Bonse, J. Quo Vadis LIPSS?—Recent and Future Trends on Laser-Induced Periodic Surface Structures. Nanomaterials 2020, 10, 1950. [Google Scholar] [CrossRef]
- Shivakoti, I.; Kibria, G.; Cep, R.; Pradhan, B.B.; Sharma, A. Laser Surface Texturing for Biomedical Applications: A Review. Coatings 2021, 11, 124. [Google Scholar] [CrossRef]
- Bronnikov, K.; Gladkikh, S.; Okotrub, K.; Simanchuk, A.; Zhizhchenko, A.; Kuchmizhak, A.; Dostovalov, A. Regulating Morphology and Composition of Laser-Induced Periodic Structures on Titanium Films with Femtosecond Laser Wavelength and Ambient Environment. Nanomaterials 2022, 12, 306. [Google Scholar] [CrossRef]
- Florian, C.; Kirner, S.V.; Krüger, J.; Bonse, J. Surface Functionalization by Laser-Induced Periodic Surface Structures. J. Laser Appl. 2020, 32, 022063. [Google Scholar] [CrossRef]
- Birnbaum, M. Semiconductor Surface Damage Produced by Ruby Lasers. J. Appl. Phys. 1965, 36, 3688–3689. [Google Scholar] [CrossRef]
- Bonse, J.; Gräf, S. Ten Open Questions about Laser-Induced Periodic Surface Structures. Nanomaterials 2021, 11, 3326. [Google Scholar] [CrossRef] [PubMed]
- Vorobyev, A.Y.; Makin, V.S.; Guo, C. Periodic Ordering of Random Surface Nanostructures Induced by Femtosecond Laser Pulses on Metals. J. Appl. Phys. 2007, 101, 034903. [Google Scholar] [CrossRef]
- Jia, T.Q.; Chen, H.X.; Huang, M.; Zhao, F.L.; Qiu, J.R.; Li, R.X.; Xu, Z.Z.; He, X.K.; Zhang, J.; Kuroda, H. Formation of Nanogratings on the Surface of a ZnSe Crystal Irradiated by Femtosecond Laser Pulses. Phys. Rev. B 2005, 72, 125429. [Google Scholar] [CrossRef]
- Bonse, J.; Gräf, S. Maxwell Meets Marangoni—A Review of Theories on Laser-Induced Periodic Surface Structures. Laser Photon Rev. 2020, 14, 1–25. [Google Scholar] [CrossRef]
- Fuentes-Edfuf, Y.; Sánchez-Gil, J.A.; Florian, C.; Giannini, V.; Solis, J.; Siegel, J. Surface Plasmon Polaritons on Rough Metal Surfaces: Role in the Formation of Laser-Induced Periodic Surface Structures. ACS Omega 2019, 4, 6939–6946. [Google Scholar] [CrossRef]
- San-Blas, A.; Martinez-Calderon, M.; Buencuerpo, J.; Sanchez-Brea, L.M.; del Hoyo, J.; Gómez-Aranzadi, M.; Rodríguez, A.; Olaizola, S.M. Femtosecond Laser Fabrication of LIPSS-Based Waveplates on Metallic Surfaces. Appl. Surf. Sci. 2020, 520, 146328. [Google Scholar] [CrossRef]
- Gao, Y.-F.; Yu, C.-Y.; Han, B.; Ehrhardt, M.; Lorenz, P.; Xu, L.-F.; Zhu, R.-H. Picosecond Laser-Induced Periodic Surface Structures (LIPSS) on Crystalline Silicon. Surf. Interfaces 2020, 19, 100538. [Google Scholar] [CrossRef]
- Cubero, A.; Martínez, E.; Angurel, L.A.; de la Fuente, G.F.; Navarro, R.; Legall, H.; Krüger, J.; Bonse, J. Effects of Laser-Induced Periodic Surface Structures on the Superconducting Properties of Niobium. Appl. Surf. Sci. 2020, 508, 145140. [Google Scholar] [CrossRef]
- Heitz, J.; Reisinger, B.; Fahrner, M.; Romanin, C.; Siegel, J.; Svorcik, V. Laser-Induced Periodic Surface Structures (LIPSS) on Polymer Surfaces. In Proceedings of the 2012 14th International Conference on Transparent Optical Networks (ICTON), IEEE, Coventry, UK, 2–5 July 2012; pp. 1–4. [Google Scholar]
- Rodríguez-Beltrán, R.I.; Paszkiewicz, S.; Szymczyk, A.; Rosłaniec, Z.; Nogales, A.; Ezquerra, T.A.; Castillejo, M.; Moreno, P.; Rebollar, E. Laser Induced Periodic Surface Structures on Polymer Nanocomposites with Carbon Nanoadditives. Appl. Phys. A Mater. Sci. Process 2017, 123, 717. [Google Scholar] [CrossRef]
- Bonse, J.; Krüger, J.; Höhm, S.; Rosenfeld, A. Femtosecond Laser-Induced Periodic Surface Structures. J. Laser Appl. 2012, 24, 042006. [Google Scholar] [CrossRef]
- Kasischke, M.; Maragkaki, S.; Volz, S.; Ostendorf, A.; Gurevich, E.L. Simultaneous Nanopatterning and Reduction of Graphene Oxide by Femtosecond Laser Pulses. Appl. Surf. Sci. 2018, 445, 197–203. [Google Scholar] [CrossRef]
- Szymborski, T.; Stepanenko, Y.; Nicinski, K.; Piecyk, P.; Berus, S.M.; Adamczyk-Poplawska, M.; Kaminska, A. Ultrasensitive SERS Platform Made via Femtosecond Laser Micromachining for Biomedical Applications. J. Mater. Res. Technol. 2021, 12, 1496–1507. [Google Scholar] [CrossRef]
- Dashtbozorg, B.; Penchev, P.; Romano, J.M.; Li, X.; Sammons, R.L.; Dimov, S.; Dong, H. Development of Surfaces with Antibacterial Durability through Combined S Phase Plasma Hardening and Athermal Femtosecond Laser Texturing. Appl. Surf. Sci. 2021, 565, 150594. [Google Scholar] [CrossRef]
- Zheng, S.; Bawazir, M.; Dhall, A.; Kim, H.E.; He, L.; Heo, J.; Hwang, G. Implication of Surface Properties, Bacterial Motility, and Hydrodynamic Conditions on Bacterial Surface Sensing and Their Initial Adhesion. Front. Bioeng. Biotechnol. 2021, 9, 643722. [Google Scholar] [CrossRef]
- Silhavy, T.J.; Kahne, D.; Walker, S. The Bacterial Cell Envelope. Cold Spring Harb. Perspect. Biol. 2010, 2, a000414. [Google Scholar] [CrossRef] [PubMed]
- Du, C.; Wang, C.; Zhang, T.; Zheng, L. Antibacterial Performance of Zr-BMG, Stainless Steel, and Titanium Alloy with Laser-Induced Periodic Surface Structures. ACS Appl. Bio Mater. 2022, 5, 272–284. [Google Scholar] [CrossRef]
- Zhao, Q.; Wu, J.; Li, Y.; Xu, R.; Zhu, X.; Jiao, Y.; Luo, R.; Ni, X. Promotion of Bone Formation and Antibacterial Properties of Titanium Coated with Porous Si/Ag-Doped Titanium Dioxide. Front. Bioeng. Biotechnol. 2022, 10, 1001514. [Google Scholar] [CrossRef]
- Medvids, A.; Onufrijevs, P.; Kaupužs, J.; Eglitis, R.; Padgurskas, J.; Zunda, A.; Mimura, H.; Skadins, I.; Varnagiris, S. Anatase or Rutile TiO2 Nanolayer Formation on Ti Substrates by Laser Radiation: Mechanical, Photocatalytic and Antibacterial Properties. Opt. Laser Technol. 2021, 138, 106898. [Google Scholar] [CrossRef]
- Segovia, P.; Wong, A.; Santillan, R.; Camacho-Lopez, M.; Camacho-Lopez, S. Multi-Phase Titanium Oxide LIPSS Formation under Fs Laser Irradiation on Titanium Thin Films in Ambient Air. Opt. Mater. Express 2021, 11, 2892. [Google Scholar] [CrossRef]
- Hanawa, T. Titanium-Tissue Interface Reaction and Its Control with Surface Treatment. Front. Bioeng. Biotechnol. 2019, 7, 170. [Google Scholar] [CrossRef]
- Tanner, M.C.; Fischer, C.; Schmidmaier, G.; Haubruck, P. Evidence-Based Uncertainty: Do Implant-Related Properties of Titanium Reduce the Susceptibility to Perioperative Infections in Clinical Fracture Management? A Systematic Review. Infection 2021, 49, 813–821. [Google Scholar] [CrossRef]
- Souza, J.G.S.; Bertolini, M.M.; Costa, R.C.; Nagay, B.E.; Dongari-Bagtzoglou, A.; Barã, V.A.R. Targeting Implant-Associated Infections: Titanium Surface Loaded with Antimicrobial. IScience 2021, 24, 102008. [Google Scholar] [CrossRef]
- Amin Yavari, S.; Castenmiller, S.M.; van Strijp, J.A.G.; Croes, M. Combating Implant Infections: Shifting Focus from Bacteria to Host. Adv. Mater. 2020, 32, 2002962. [Google Scholar] [CrossRef]
- Li, X.; Sun, L.; Zhang, P.; Wang, Y. Novel Approaches to Combat Medical Device-Associated Biofilms. Coatings 2021, 11, 294. [Google Scholar] [CrossRef]
- Goodfellow Cambridge Ltd. Available online: https://www.goodfellow.com/ (accessed on 1 June 2023).
- Jaggessar, A.; Shahali, H.; Mathew, A.; Yarlagadda, P.K.D.V. Bio-Mimicking Nano and Micro-Structured Surface Fabrication for Antibacterial Properties in Medical Implants. J. Nanobiotech. 2017, 15, 64. [Google Scholar] [CrossRef] [PubMed]
- Gečys, P.; Vinčiunas, A.; Gedvilas, M.; Kasparaitis, A.; Lazdinas, R.; Račiukaitis, G. Ripple Formation by Femtosecond Laser Pulses for Enhanced Absorptance of Stainless Steel. J. Laser Micro Nanoeng. 2015, 10, 129–133. [Google Scholar] [CrossRef]
- Schell, F.; Alamri, S.; Hariharan, A.; Gebert, A.; Lasagni, A.F.; Kunze, T. Fabrication of Four-Level Hierarchical Topographies through the Combination of LIPSS and Direct Laser Interference Pattering on near-Beta Titanium Alloy. Mater. Lett. 2022, 306, 130920. [Google Scholar] [CrossRef]
- Proch, S.; Yoshino, S.; Takahashi, N.; Seki, J.; Kosaka, S.; Kodama, K.; Morimoto, Y. The Native Oxide on Titanium Metal as a Conductive Model Substrate for Oxygen Reduction Reaction Studies. Electrocatalysis 2018, 9, 608–622. [Google Scholar] [CrossRef]
- Huang, H.; Zhang, P.; Yu, Z.; Zhang, X.; Shen, L.; Shi, H.; Yan, H.; Wang, L.; Tian, Y. Effects of Periodic Surface Structures Induced by Femtosecond Laser Irradiation on the Antibacterial Properties of Zr-Based Amorphous Material. Optik 2022, 268, 169760. [Google Scholar] [CrossRef]
- Balachandran, U.; Eror, N.G. Raman Spectra of Titanium Dioxide. J. Solid State Chem. 1982, 42, 276–282. [Google Scholar] [CrossRef]
- Landis, E.C.; Phillips, K.C.; Mazur, E.; Friend, C.M. Formation of Nanostructured TiO2 by Femtosecond Laser Irradiation of Titanium in O2. J. Appl. Phys. 2012, 112, 063108. [Google Scholar] [CrossRef]
- Peng, W.C.; Chen, Y.C.; He, J.L.; Ou, S.L.; Horng, R.H.; Wuu, D.S. Tunability of P- and n-Channel TiOx Thin Film Transistors. Sci. Rep. 2018, 8, 9255. [Google Scholar] [CrossRef] [PubMed]
- Jalil, S.A.; Akram, M.; Bhat, J.A.; Hayes, J.J.; Singh, S.C.; ElKabbash, M.; Guo, C. Creating Superhydrophobic and Antibacterial Surfaces on Gold by Femtosecond Laser Pulses. Appl. Surf. Sci. 2020, 506, 144952. [Google Scholar] [CrossRef] [PubMed]
- Lutey, A.H.A.; Gemini, L.; Romoli, L.; Lazzini, G.; Fuso, F.; Faucon, M.; Kling, R. Towards Laser-Textured Antibacterial Surfaces. Sci. Rep. 2018, 8, 10112. [Google Scholar] [CrossRef] [PubMed]

| No | Laser Fluence, mJ/cm2 | Spot Size, μm | Laser Rep. Rate, kHz | Scanning Speed, mm/s | Hatch, μm |
|---|---|---|---|---|---|
| T4 | 63 | 80 | 600 | 1 | 4 |
| T8 | 63 | 80 | 600 | 1 | 8 |
| T12 | 63 | 80 | 600 | 1 | 12 |
| T16 | 63 | 80 | 600 | 1 | 16 |
| T12A | 254 | 40 | 600 | 2 | 12 |
| T12WL | 106 | 40 | 600 | 2 | 12 |
| Sample | Tref | 4 μm | 8 μm | 12 μm | 16 μm |
|---|---|---|---|---|---|
| Contact angle | 79.5 | 136.5 | 112.0 | 98.7 | 104.5 |
| (°) | ±2.3 | ±2.4 | ±1.5 | ±3.0 | ±2.9 |
Disclaimer/Publisher’s Note: The statements, opinions and data contained in all publications are solely those of the individual author(s) and contributor(s) and not of MDPI and/or the editor(s). MDPI and/or the editor(s) disclaim responsibility for any injury to people or property resulting from any ideas, methods, instructions or products referred to in the content. |
© 2023 by the authors. Licensee MDPI, Basel, Switzerland. This article is an open access article distributed under the terms and conditions of the Creative Commons Attribution (CC BY) license (https://creativecommons.org/licenses/by/4.0/).
Share and Cite
Grase, L.; Onufrijevs, P.; Rezevska, D.; Racenis, K.; Skadins, I.; Karosas, J.; Gecys, P.; Iesalnieks, M.; Pludons, A.; Kroica, J.; et al. Effect of Femtosecond Laser-Irradiated Titanium Plates on Enhanced Antibacterial Activity and Preservation of Bacteriophage Stability. Nanomaterials 2023, 13, 2032. https://doi.org/10.3390/nano13142032
Grase L, Onufrijevs P, Rezevska D, Racenis K, Skadins I, Karosas J, Gecys P, Iesalnieks M, Pludons A, Kroica J, et al. Effect of Femtosecond Laser-Irradiated Titanium Plates on Enhanced Antibacterial Activity and Preservation of Bacteriophage Stability. Nanomaterials. 2023; 13(14):2032. https://doi.org/10.3390/nano13142032
Chicago/Turabian StyleGrase, Liga, Pavels Onufrijevs, Dace Rezevska, Karlis Racenis, Ingus Skadins, Jonas Karosas, Paulius Gecys, Mairis Iesalnieks, Arturs Pludons, Juta Kroica, and et al. 2023. "Effect of Femtosecond Laser-Irradiated Titanium Plates on Enhanced Antibacterial Activity and Preservation of Bacteriophage Stability" Nanomaterials 13, no. 14: 2032. https://doi.org/10.3390/nano13142032
APA StyleGrase, L., Onufrijevs, P., Rezevska, D., Racenis, K., Skadins, I., Karosas, J., Gecys, P., Iesalnieks, M., Pludons, A., Kroica, J., & Raciukaitis, G. (2023). Effect of Femtosecond Laser-Irradiated Titanium Plates on Enhanced Antibacterial Activity and Preservation of Bacteriophage Stability. Nanomaterials, 13(14), 2032. https://doi.org/10.3390/nano13142032

